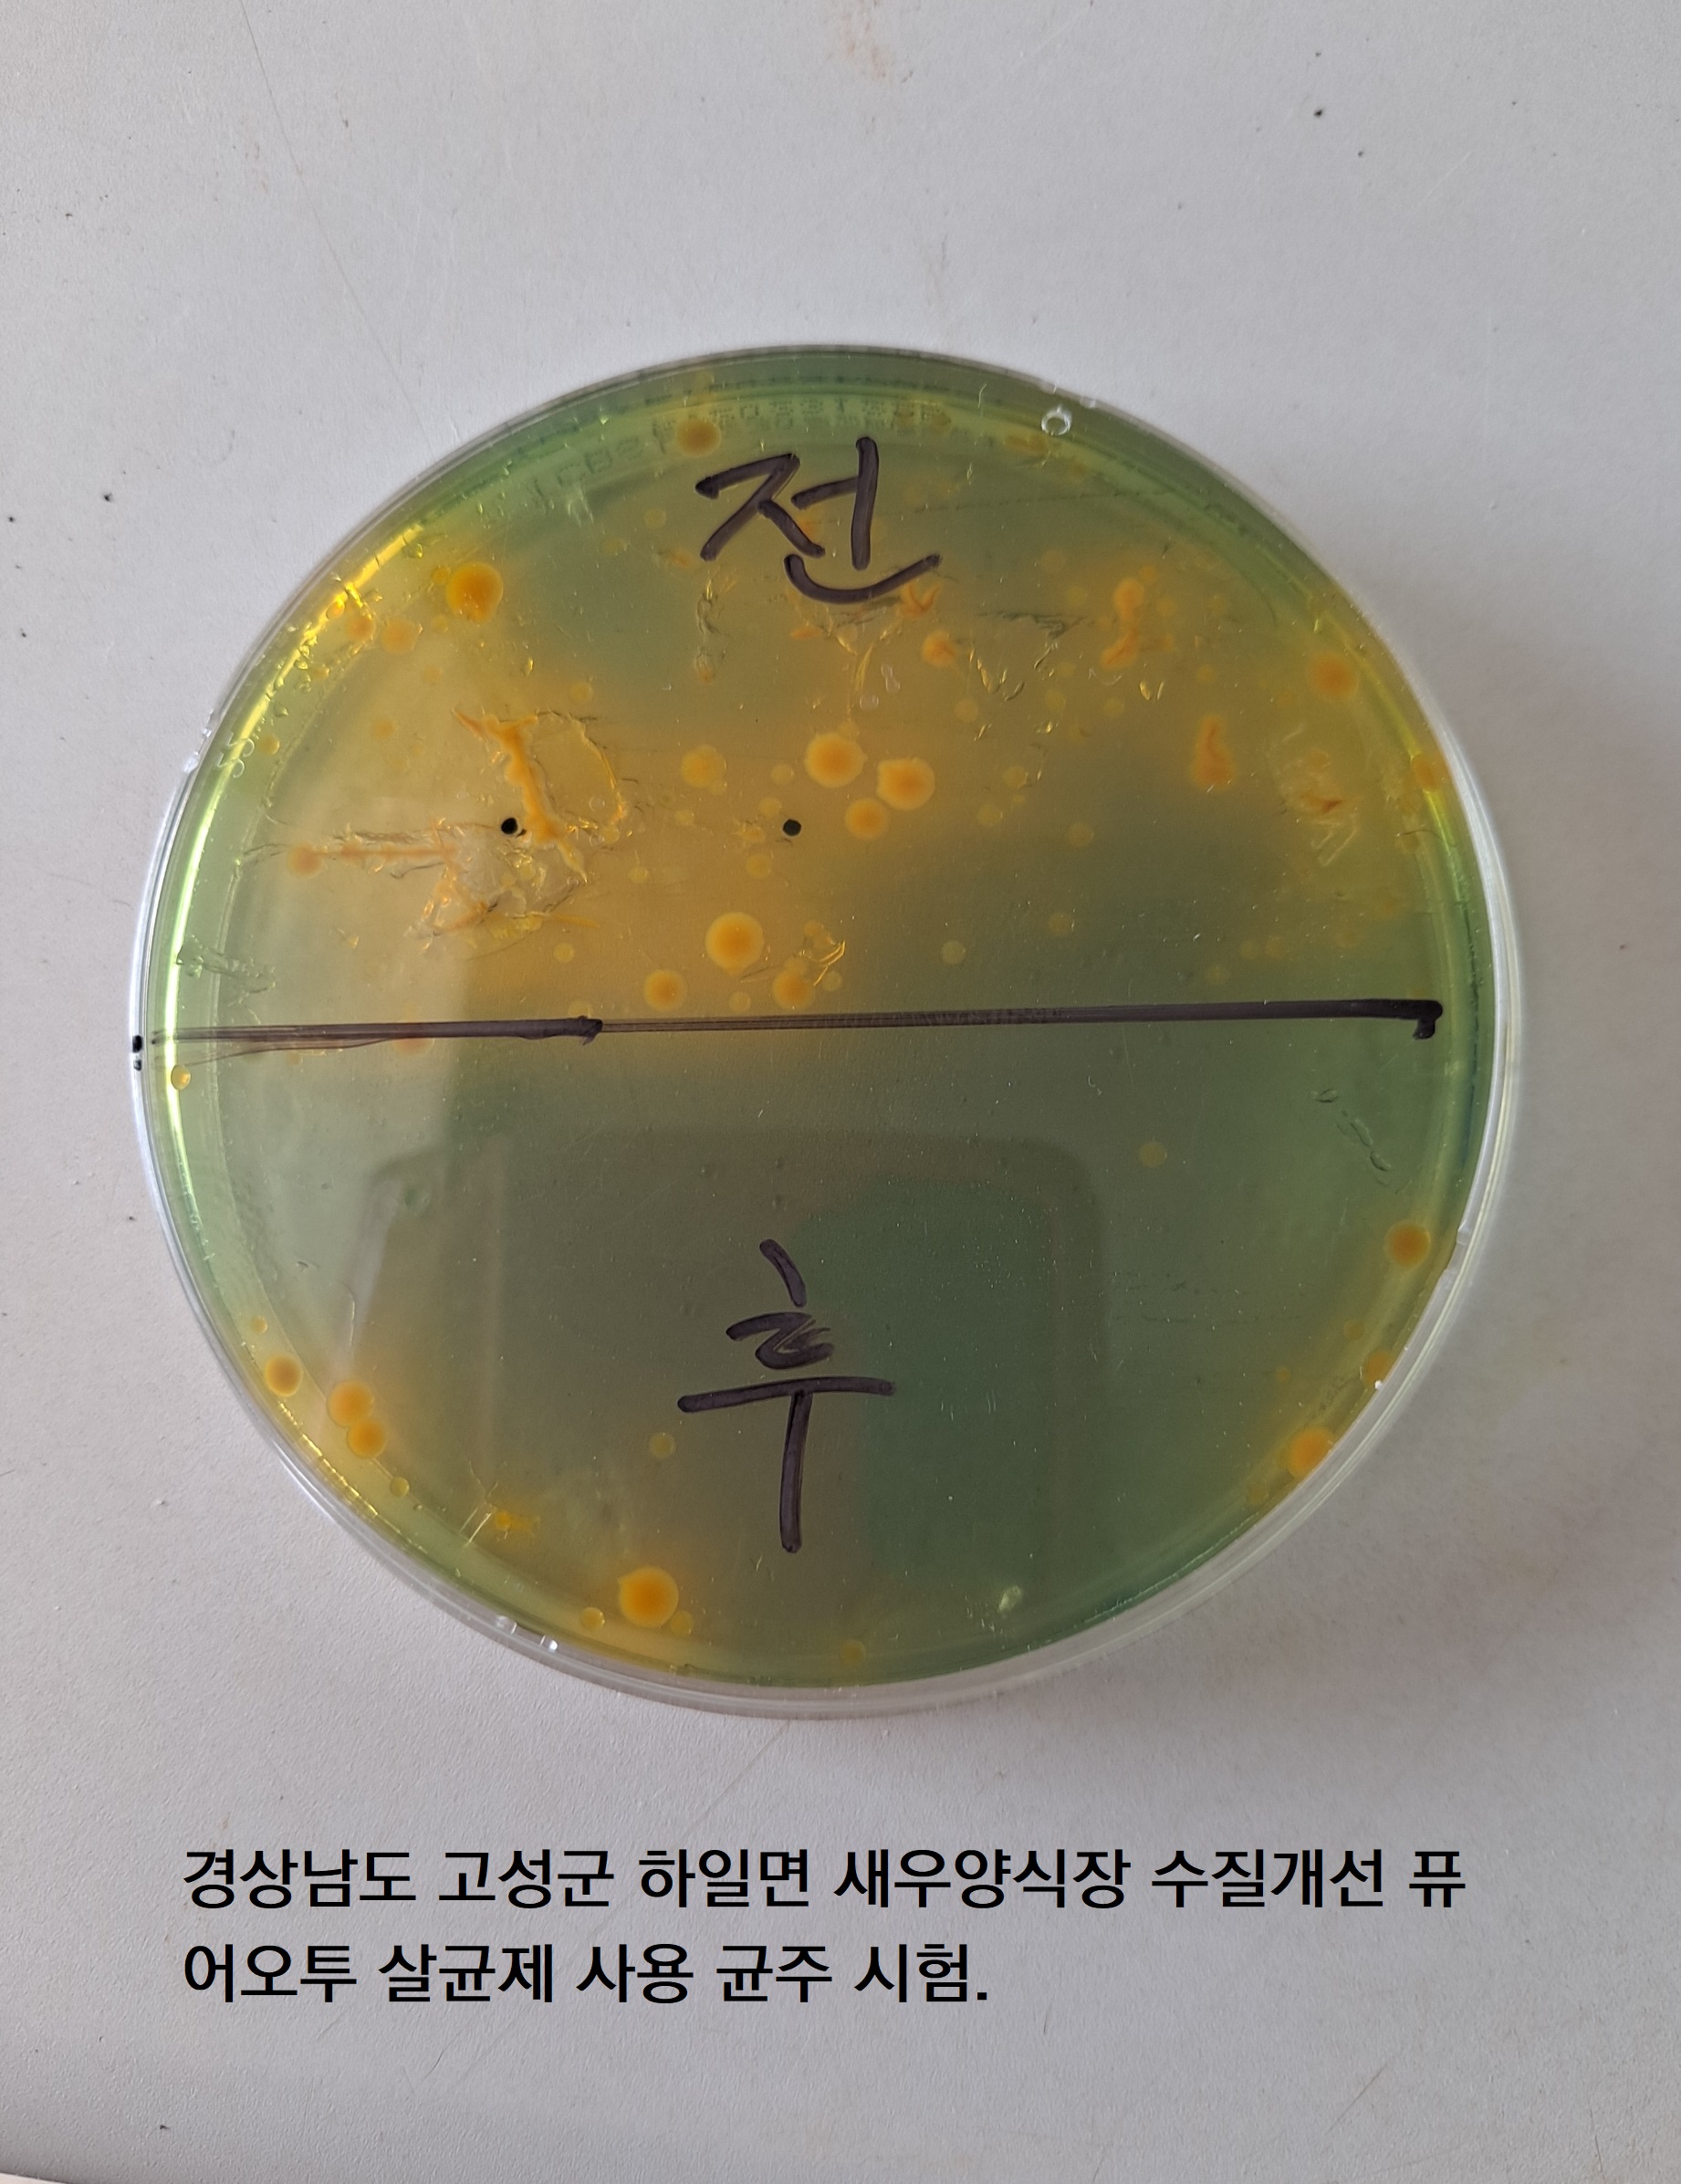

상세 컨텐츠
본문

'나의 이야기' 카테고리의 다른 글
| 퓨어오투 이산화염소수 새우양식장 시험결과 (0) | 2024.05.02 |
|---|---|
| 퓨어오투 이산화염소 양계농장 소독 (0) | 2024.04.29 |
| EM미생물의 실체 (0) | 2024.03.14 |
| 퓨어오투 이산화염소수 살균제 새우양식장 사용 (0) | 2024.01.18 |
| 퓨어오투 이산화염소 양봉산업 꿀벌 질병예방 치료 (0) | 2023.09.11 |
| 퓨어오투 이산화염소수 새우양식장 시험결과 (0) | 2024.05.02 |
|---|---|
| 퓨어오투 이산화염소 양계농장 소독 (0) | 2024.04.29 |
| EM미생물의 실체 (0) | 2024.03.14 |
| 퓨어오투 이산화염소수 살균제 새우양식장 사용 (0) | 2024.01.18 |
| 퓨어오투 이산화염소 양봉산업 꿀벌 질병예방 치료 (0) | 2023.09.11 |
댓글 영역